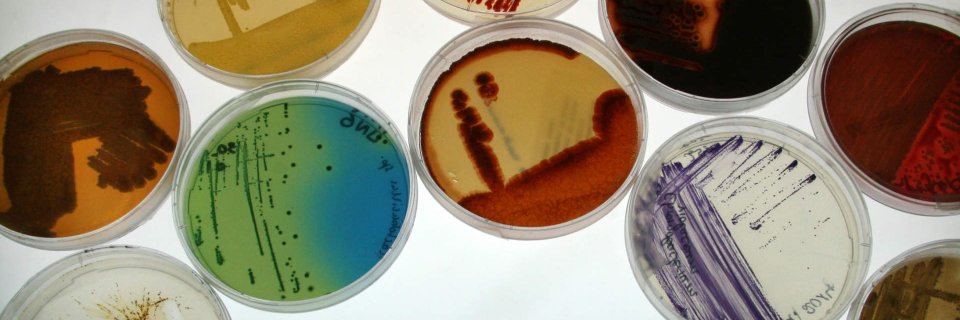
BacDive banner

BacDive retweetledi

Today we official start our activities together with several other new #NFDI consortia. We are proud to be part of the @NFDI_de family and are looking forward to support our research community. Stay tuned. nfdi4microbiota.de/index.php/2021… #NFDIrocks #RDM #Microbiology #OpenScience
GIF
English